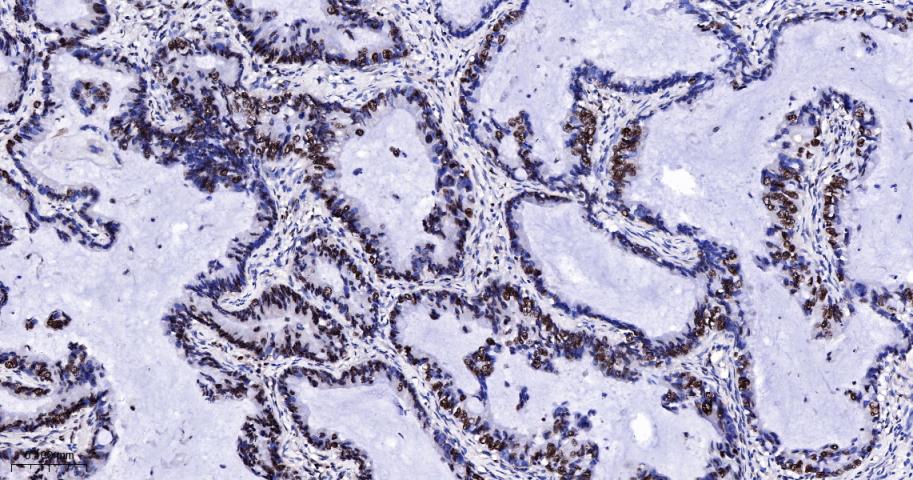
周期素E重组兔单抗
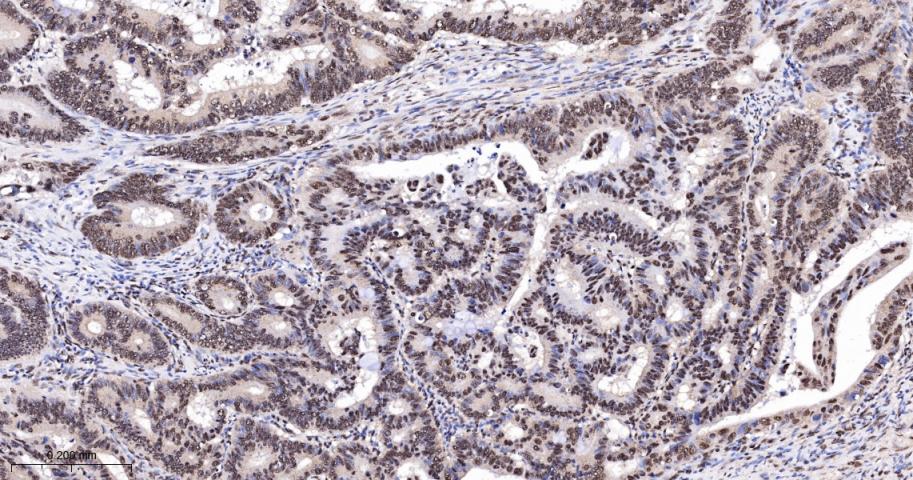
周期素E重组兔单抗

周期素E重组兔单抗
Rrmab?兔单抗

货号:bsm-52048R
产品详情
相关标记
相关产品
相关文献
常见问题
概述
产品编号
bsm-52048R
产品类型
重组兔单抗
英文名称
Cyclin E1 Recombinant Rabbit mAb
中文名称
周期素E重组兔单抗
英文别名
CCNE; pCCNE1; CycE1; CYCLE; CCNE1_HUMAN; CCNE1; CCNE1_MOUSE; CCNE1_RAT;
抗体来源
Rabbit
免疫原
A synthesized peptide derived from human Cyclin E1: 350-410
亚型
IgG
性状
Liquid
纯化方法
affinity purified by Protein A
克隆类型
Recombinant
克隆号
4H7
理论分子量
45 kDa
浓度
1mg/ml
储存液
0.01M TBS (pH7.4) with 1% BSA, 0.02% Proclin300 and 50% Glycerol.
研究领域
SWISS
Gene ID
保存条件
Shipped at 4℃. Store at -20℃ for one year. Avoid repeated freeze/thaw cycles.
注意事项
This product as supplied is intended for research use only, not for use in human, therapeutic or diagnostic applications.
数据库链接
产品介绍
细胞周期素E是调控细胞G-1→S期转变的关键因素。由于在多种肿瘤中的不适当表达,细胞周期素E现在已明确为原癌基因。
背景资料
Cyclin E is a regulatory subunit of Cdk2 and controls G1 / S transition during the mammalian cell cycle. Multiple isoforms of Cyclin E are only expressed in tumors but not in normal tissue, suggesting a post transcriptional regulation of Cyclin E. In vitro analyses indicated that these truncated variant isoforms of Cyclin E are able to phosphorylate histone H1. Alterations in the Cyclin E protein have been implicated as indicators of worse prognosis in various cancers.

产品应用
| 应用 | 已检合格种属 | 预测种属 | 推荐稀释比例 |
|---|---|---|---|
| WB | Human | 1:500-2000 | |
| IHC-P | Human | 1:100-500 | |
| IHC-F | Human | 1:100-500 | |
| IF | Human | 1:100-500 | |
| ICC/IF | Human | 1:50-200 |
交叉反应
交叉反应: Human
相关产品
暂无相关产品
靶标
基因名
CCNE1
蛋白名
G1/S-specific cyclin-E1
亚基
Interacts with a member of the CDK2/CDK protein kinases to form a serine/threonine kinase holoenzyme complex. The cyclin subunit imparts substrate specificity to the complex. Found in a complex with CDK2, CABLES1 and CCNA1 (By similarity). Part of a complex consisting of UHRF2, CDK2 and CCNE1. Interacts directly with UHRF2; the interaction ubiquitinates CCNE1 and appears to occur independently of CCNE1 phosphorylation.
亚细胞定位
Nucleus.
组织特异性
Highly expressed in testis and placenta. Low levels in bronchial epithelial cells.
翻译后修饰
Phosphorylation of Thr-395 by GSK3 and of Ser-399 by CDK2 accelerates degradation via the ubiquitin proteasome pathway. Phosphorylated upon DNA damage, probably by ATM or ATR.
相似性
Belongs to the cyclin family. Cyclin E subfamily.
功能
Essential for the control of the cell cycle at the G1/S (start) transition.
标记抗体
暂无标记数据
同靶标产品
暂无同靶标产品
相关文献
提示: 发表研究结果有使用 bsm-52048R 时请让我们知道,以便我们可以引用参考文章。作为回馈,资料提供者将获得我们送上的小礼品。
具体参考文献:bsm-52048R 被引用于2文献中
暂无相关文献
常见问题
暂无常见问题